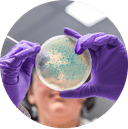
Péče o mikrobiom

Microbiome test
Zjistěte skutečný stav svých střev
Microbiome test je molekulárně biologická analýza na základě vzorku střevního mikrobiomu, která pomáhá odhalit, zda není narušený stav vašeho střevního systému. Vědecká analýza detekuje a porovnává zastoupení vybraných skupin bakterií ve střevě, zároveň je schopna určit i jejich věk. Cílem produktu je včasně předejít závažným následkům, které může mikrobiom ve střevě napáchat, a navrhnout řešení prevence či zastavení nepříznivého trendu.